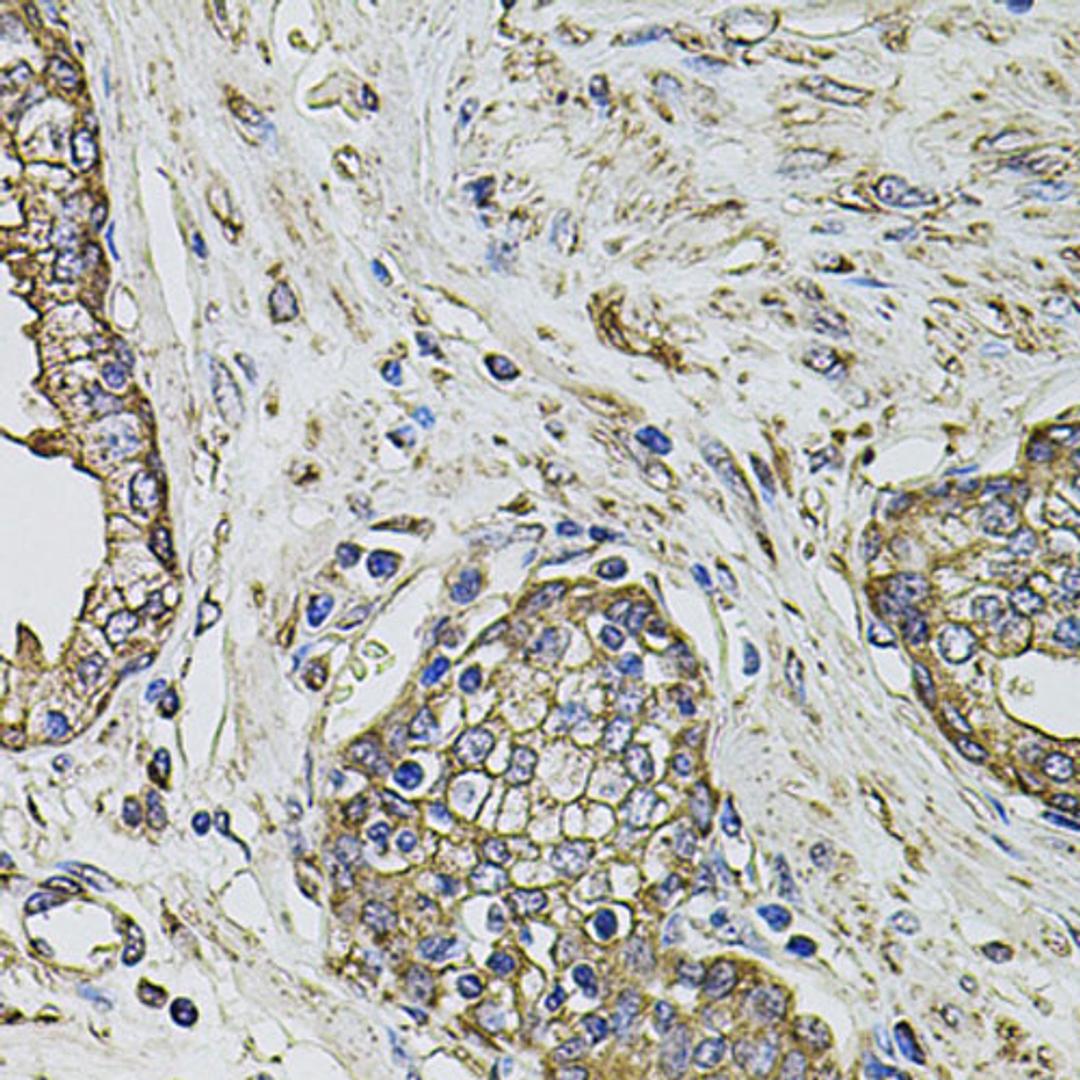
Immunohistochemistry - PTHLH antibody (A12492)

PTHLH Rabbit pAb
Product Details
- Cat. No.
- A12492
- Type
- Primary Antibody
- Clonality
- Polyclonal
- Host
- Rabbit

The supplier does not provide quotations for this antibody through SelectScience. You can search for similar antibodies in our Antibody Directory.
Description
The protein encoded by this gene is a member of the parathyroid hormone family. This hormone, via its receptor, PTHR1, regulates endochondral bone development and epithelial-mesenchymal interactions during the formation of the mammary glands and teeth. It is responsible for most cases of humoral hypercalcemia of malignancy, and mutations in this gene are associated with brachydactyly type E2 (BDE2). Alternatively spliced transcript variants have been found for this gene. There is also evidence for alternative translation initiation from non-AUG (CUG and GUG) start sites, downstream of the initiator AUG codon, resulting in nuclear forms of this hormone.
Biological Information
- Clonality: Polyclonal
- Host: Rabbit
- Reactivity: Human